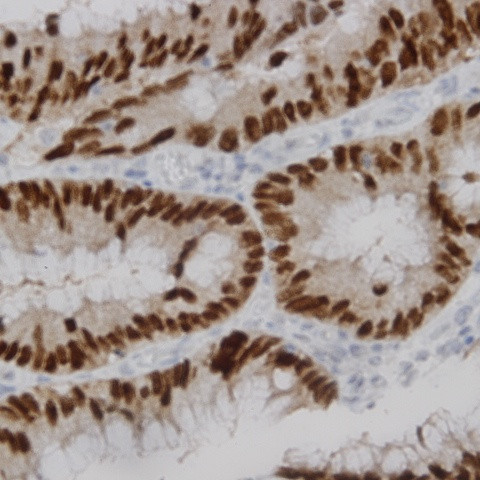
Phospho-c-Fos (Thr232) Antibody in Immunohistochemistry (Paraffin) (IHC (P))

Search
AbboMax
Phospho-c-Fos (Thr232) Polyclonal Antibody
{{$productOrderCtrl.translations['antibody.pdp.commerceCard.promotion.promotions']}}
{{$productOrderCtrl.translations['antibody.pdp.commerceCard.promotion.viewpromo']}}
{{$productOrderCtrl.translations['antibody.pdp.commerceCard.promotion.promocode']}}: {{promo.promoCode}} {{promo.promoTitle}} {{promo.promoDescription}}. {{$productOrderCtrl.translations['antibody.pdp.commerceCard.promotion.learnmore']}}
图: 1 / 2
Phospho-c-Fos (Thr232) Antibody (620-760) in IHC (P)


产品信息
620-760
种属反应
宿主/亚型
分类
类型
抗原
偶联物
形式
浓度
规格
纯化类型
保存液
内含物
保存条件
运输条件
产品详细信息
Positive control: Skin
Cellular location: Nucleus.
靶标信息
FBJ murine osteosarcoma viral oncogene homolog is commonly known as Cellular protooncogene Fos (c-Fos). It belongs to the fos transcription factor family and is encoded by the C-FOS gene located on chromosome 14. c-Fos heterodimerizes with c-Jun to form the Activator Protein -1 (AP-1) transcription factor which regulates transcription of several genes that play an important role in cellular signal transduction, cell proliferation and differentiation. c-Fos has been shown to be phosphorylated by various stimuli including growth factors and insulin at atleast seven different sites. The best known upstream kinase for phosphorylation at Threonine 232 is ERK MAPK which regulates localization of c-Fos to the nucleus and is thus important for c-Fos induced transcriptional activity.
仅用于科研。不用于诊断过程。未经明确授权不得转售。
篇参考文献 (0)
生物信息学
蛋白别名: activator protein 1; c-fos oncogene; cellular oncogene c-fos; Cellular oncogene fos; FBJ murine osteosarcoma viral (v-fos) oncogene homolog (oncogene FOS); FBJ murine osteosarcoma viral oncogene homolog; FBJ osteosarcoma oncogene; FOS; Fos proto-oncogene, AP-1 trancription factor subunit; Fos proto-oncogene, AP-1 transcription factor subunit; G0/G1 switch regulatory protein 7; Protein c-Fos; Proto-oncogene c-Fos; proto-oncogene cFOS; proto-oncogene protein c-fos; Transcription factor AP-1 subunit c-Fos; unnamed protein product; v-fos FBJ murine osteosarcoma viral oncogene homolog
基因别名: AP-1; C-FOS; cFos; D12Rfj1; FOS; G0S7; p55
UniProt ID: (Human) P01100, (Mouse) P01101, (Rat) P12841
Entrez Gene ID: (Human) 2353, (Mouse) 14281, (Rat) 314322